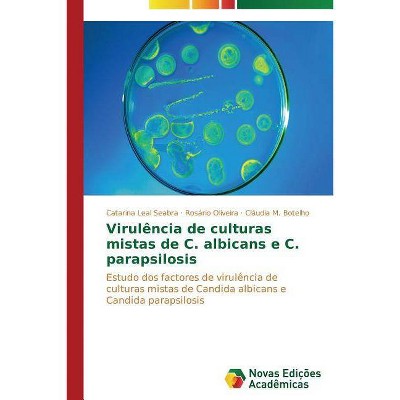
Virulência de culturas mistas de C. albicans e C. parapsilosis - by  Seabra Catarina Leal (Paperback)

Te He Buscado - by Catarina Yoana Ribas D'Marquese (Paperback)

Store: Target
Last Price: 9.99 USD
Similar Products
Products of same category from the store
AllProduct info
<p/><br></br><p><b> Book Synopsis </b></p></br></br><p><br> "Te he buscado: es una historia de un amor que te daño y de un amor que te redimió, un amor que no tuvo fin. Es una historia donde lo dulce te sabe amargo es un caminar por un valle de sombra de muerte donde aún herido y desangrado tienes que seguir adelante. <p/> Es ahí en ese lugar donde te encuentras perdido, no sabes el camino, pero El Eterno te hace brillar y eres inolvidable. Y cuando menos pensabas el amor te encuentra y te abraza y se va y te rescata.</p>
Price History
Price Archive shows prices from various stores, lets you see history and find the cheapest. There is no actual sale on the website. For all support, inquiry and suggestion messages communication@pricearchive.us